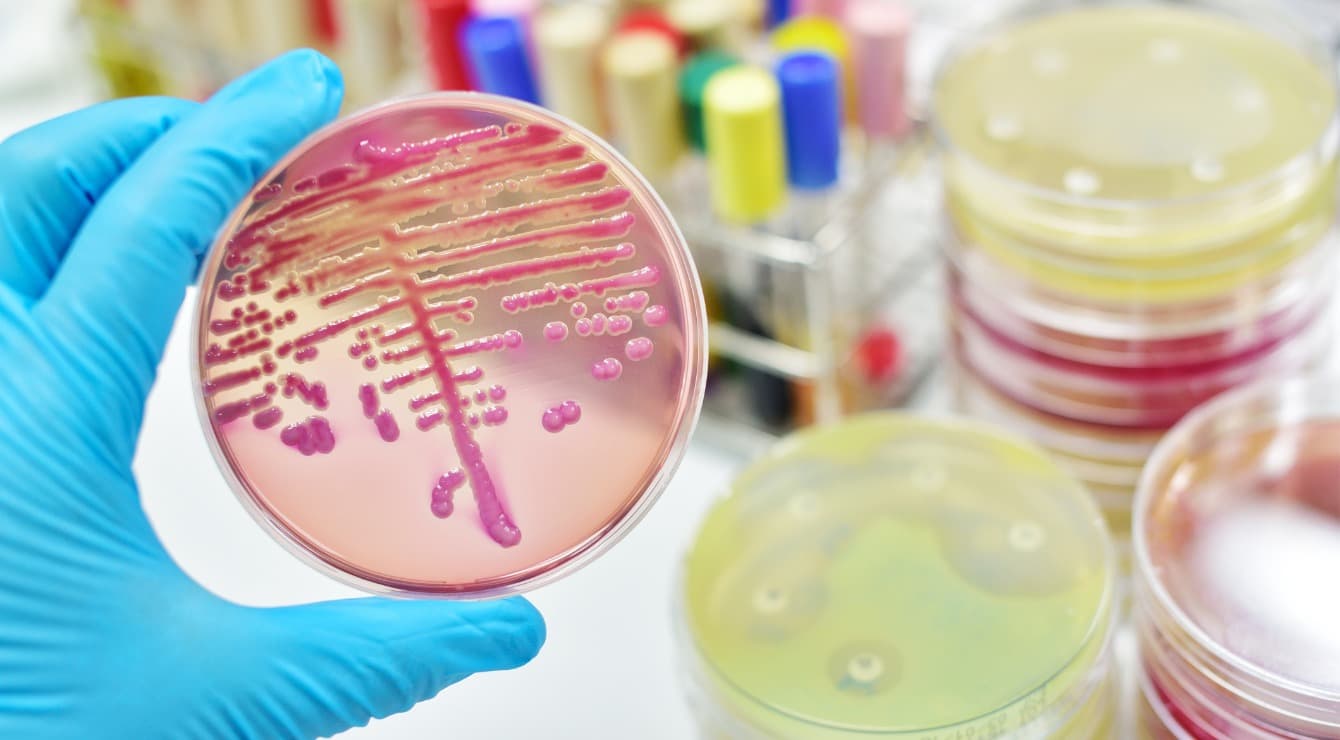
Omon qolgan sepsis: hayot va martabani o’zgartiradigan tajriba

O'limga yaqin tajriba
To'liq muddatli homiladorlik va asoratsiz tug'ilish tug'ruqdan uch soat o'tgach, mening sog'lom yangi tug'ilgan qizim to'satdan qo'limda ko'karib ketdi. Bir necha soniya ichida uni reanimatsiya qilish uchun neonatal intensiv terapiya bo'limiga (NICU) olib ketishdi. Bu bizning hayotimizni o'zgartiradigan sayohatning boshlanishi ekanligini bilmagan edim.
Qizim Elli va menga A guruhidagi streptokokklar kelib chiqqan sepsis tashxisi qo'yildi. Ushbu og'ir kasallik ikkalamiz uchun ham hayotni saqlab qolish choralarini talab qildi, jumladan, mintaqaviy shifoxonamizdan uning og'ir kasalligiga mos keladigan kattaroq kasalxonaga vertolyotda olib ketish. Elli NICUda 21 kun o'tkazdi, sakkizta lomber ponksiyon qildi, ikkita qon quydi va periferik o'rnatilgan markaziy kateter liniyasi orqali meningitli ampitsillin dozasini qo'ydi. Bular uning sakkizinchi yilida boshidan kechirgan ko'plab tibbiy muolajalardan faqat bir qismi edi. Ammo sepsis bilan kasallangan yagona biz emasmiz. Darhaqiqat, omon qolgan ko'plab odamlar butun umri davomida sepsis oqibatlarini boshdan kechiradilar. Sepsis - bu organizmning infektsiyaga haddan tashqari reaktsiyasi natijasida yuzaga keladigan hayot uchun xavfli kasallik. Ushbu infektsiya bakterial, virusli, parazitar yoki qo'ziqorin bo'lishi mumkin. Siz siydik yo'llari infektsiyasi, operatsiyadan keyingi infektsiya, it tishlashi, COVID-19 va bizning holatimizda bo'lgani kabi, streptokok tomoq kasalligidan sepsis rivojlanishi mumkin.
Har 2,8 soniyada dunyo bo'ylab kimdir sepsisdan vafot etadi. Bu har yili 47 dan 50 milliongacha odamga ta'sir qiladi; faqat 2017 yilda 11 million o'lim sepsis bilan bog'liq. O'limga yaqin bo'lgan bu tajribadan oldin men sepsis so'zi nimani anglatishini bilmasdim. Va, albatta, men va oilam uchun uzoq muddatli ta'sirlar qanday bo'lishini bilmasdim.
Imkonsiz narsani "sotish" vazifasi
Men aloqa mutaxassisiman. Hikoya san'ati har doim mening rolimning asosiy qismi, g'oyalar, his-tuyg'ular va tajribalarni etkazish vositasi bo'lib kelgan. Sepsis bilan bog'liq tajribamizdan so'ng, hikoya qilish chuqur shaxsiy bo'lib qoldi va mening marketolog sifatidagi rolimga bo'lgan munosabatimni o'zgartirdi.
Endi men sepsis haqida ma'lumot sotaman - bu nima, uni qanday aniqlash va uni qanday qilib to'xtatish kerak. Biroq, sepsis dunyodagi eng yomon "bozor" kasalliklaridan biridir. Sepsis belgilari boshqa holatlar kabi bo'lishi mumkin, bu ularni tanib olish va tashxis qo'yishni qiyinlashtiradi. Ba'zi odamlar sepsis alomatlarini jiddiyligini tushunmasdan gripp yoki sovuq deb hisoblashlari mumkin.
Ba'zi odamlar sepsis alomatlarini jiddiyligini tushunmasdan gripp yoki sovuq deb hisoblashlari mumkin.
Ushbu qiyinchiliklarni va xabardorlikning etishmasligini tan olib, men Kanadaning birinchi va eng yirik provintsiyasi bo'ylab to'liq integratsiyalashgan sog'liqni saqlash tizimi Alberta Health Services, shuningdek, bir nechta tadqiqot tarmoqlarida bemor va oila maslahatchisi sifatida ko'ngilli sifatida ko'proq ma'lumot olish uchun sayohatga chiqdim. sepsisni aniqlash, davolash va oldini olishga qaratilgan. Hozir tadqiqot tarmog'ida Aloqa bo'yicha dastur menejeri sifatida to'la vaqtli ish bilan bandman, agar sotilmasa, siz ushbu maqolani o'qiganingizda 85 kishining o'limiga sabab bo'ladigan kasallikni marketing bilan shug'ullanaman.
Sog'liqni saqlash tadqiqotida bemor hamkorlari
Men birinchi bemor sherigim bilan Zoom orqali tanishdim. Biz sepsis bilan bog'liq tajribalarimiz haqida suhbatlashdik. Bu qanday sodir bo'ldi, kim ta'sir qildi va bizning hayotimiz abadiy o'zgardi. Men gaplashgan har bir kishi boshqa hech kim yoki sevgan odam o'zlarida bo'lgan narsalarni boshdan kechirishini xohlamadi.
Mening shifolashimning bir qismi bemorni jalb qilish dunyosiga sho'ng'ish orqali keldi. Bemor va aloqa bo'yicha mutaxassis sifatida mening rolim to'liq aylana boshladi va endi hayotiy tajribaga ega bo'lgan ko'proq odamlarni sepsis tadqiqotiga jalb qilmoqda.
Bemorlarga yo'naltirilgan tadqiqotlar strategiyasi (SPOR) bemorlarni, tadqiqotchilarni, klinisyenlarni va siyosatchilarni birlashtirgan holda bemorlarni tadqiqotga integratsiya qilish strategiyalarini amalga oshirdi.
Bemorlarni sog'liqni saqlash tadqiqotlari va parvarishlash tashabbuslariga jalb qilish o'n yildan beri mavjud bo'lsa-da, bemorlarni jalb qilish dunyosi tizim qo'llab-quvvatlaganidan tezroq rivojlanmoqda. Aksariyat hollarda jalb qilish imkoniyatlari cheklanganligicha qolmoqda. Ko'pincha, bemor hamkorlari birgalikda loyihalash jarayonining bir qismi bo'lish va bemor boshchiligidagi tadqiqotlar bilan shug'ullanish o'rniga, grant yakunlari bo'yicha bilimlarni tarjima qilish faoliyatining bir qismi sifatida faqat hamkorlar sifatida kiritiladi.
Bemor hamkorlari uchun imkoniyatlar jalb qilish va o'qitishning ortib borayotgan darajasini aks ettirishi va moliyalashtirish va tadqiqot o'tkazish qobiliyatini o'z ichiga olishi kerak. Faqat katakchani belgilab qo'ymang.
Bemorlar bilan hamkorlik qilish imkoniyatlari
Bemor hamkorlari sog'liqni saqlash tadqiqotlari va parvarishining ajralmas qismidir. SPORning qo'llab-quvvatlash bo'linmalari va tarmoqlari kabi bemorlarni jalb qilishni qo'llab-quvvatlash bo'yicha ko'plab tashabbuslarga qaramay, buni qanday qilib mazmunli va yaxshi bajarish bo'yicha hali ham ish bor. Bunga yangi dasturlarni ishlab chiqish va mavjudlarini yaxshilashga yordam berish uchun tajribaga ega bo'lganlarni tinglash va o'rganish kiradi.
O'limga yaqin tajriba orqali ushbu tadqiqot dunyosiga majbur bo'lish menga ko'p narsalarni, jumladan, bizning hikoyamiz va tajribamizning ahamiyati va qiymatini o'rgatdi. Men sepsisni boshdan kechirgan aloqa mutaxassisiman va men har 2,8 soniyada bir odamni o'ldiradigan kasallikni "bozor qilish" uchun to'g'ri odam bo'lishim mumkin.

![Sog’liqni saqlashda ma’naviyat kuchini ochish [PODCAST]](/_next/image/?url=https%3A%2F%2Fbackend.kasallik.uz%2Fwp-content%2Fuploads%2F2023%2F05%2FUnveiling-the-power-of-spirituality-in-health-care.jpg&w=3840&q=75)
Javoblar (0 )